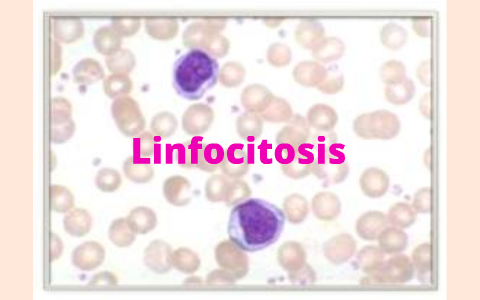
Linfocitosis by alejandra herrera on Prezi

La linfocitosis es el aumento de la cantidad o la proporción de linfocitos en la sangre. Los linfocitos son un tipo de glóbulo blanco (leucocito). La proporción normal de linfocitos dentro del total de los leucocitos varía entre 20 y 40%, y por lo tanto, una proporción que supere el 40%, cuantificado en laboratorio de análisis clínico, determinaría una linfocitosis relativa, y en contrapartida, cuando la cifra fuese inferior al 20% nos encontraríamos frente a una linfocitopenia relativa.
Diagnóstico
Una linfocitosis solo se puede llegar a diagnosticar con un análisis de sangre en laboratorio clínico, mediante un hemograma completo que en la actualidad, muchos están totalmente automatizados.
Se habla de linfocitosis en los adultos, cuando la cifra absoluta de linfocitos es superior a 4 mil/mm³ (4 000/mm³). Según otros un recuento notablemente mayor que 3 000 linfocitos en un microlitro (µL),[1][2] (o
4 × 109/L).[3][4]
En los niños, el valor citado de linfocitos es superior al de los adultos (bebés de un año de edad: 5-7 mil/mm³), diagnosticándose como tal solo cuando el recuento sea superior a 9 mil/mm³ en los infantes, y a 7 mil/mm³ en niňos mayores.
Clasificación
- Linfocitosis policlonal: Es aquella producida, generalmente, en forma consecuente a un proceso inflamatorio y/o infeccioso.
- Linfocitosis monoclonal: Generalmente reflejan una enfermedad proliferativa, en la cual el número de linfocitos está aumentado a causa de un defecto intrínseco de la población linfoide.
Causas
Síndromes mononucleares
Se caracterizan clínicamente por fiebre y linfocitos atípicos en sangre (deberían superar el 10 % del total linfocitario para considerarlos significativos). Las dos causas más frecuentes de mononucleosis son la infección por el virus de Epstein-Barr (VEB), detectándose con una prueba de anticuerpos heterófilos positiva, y por la infección por citomegalovirus (CMV) y otras que se suelen incluir como causantes de linfocitosis, siendo estas la toxoplasmosis, por adenovirus, por VIH, brucelosis, rubéola, varicela, por virus herpes simple, hepatitis víricas, tuberculosis, por ricketsias o paludismo, todas las cuales darían un Monospot negativo, por lo cual habría que hacer un diagnóstico deferencial entre estas, teniendo en cuenta también los falsos negativos que pudieren producirse con la Mononucleosis infecciosa.
Leucemia linfática crónica
Es la causa más frecuente de linfocitosis con un recuento de más de 5 mil/mm³. Es el tipo más frecuente de leucemia en el adulto anciano, con mayor incidencia en el hombre que en la mujer. Se manifiesta con una proliferación clonal de linfocitos B, de aspecto maduro. Los signos y síntomas más frecuentes son la presencia de adenopatías generalizadas, astenia y pérdida de peso. No es infrecuente una historia previa de infecciones recurrentes, causadas por la inmunodepresión que suelen presentar estos enfermos.
Actitud clínica
Una vez determinado el hemograma que denotara una posible leucocitosis, hacer repetir la prueba para estar seguro de que no hubo un error en la toma de muestras o en el proceso cuantificador.
Diferenciar si la linfocitosis es debido a un trastorno benigno consecuente a una infección, generalmente vírica, o de un proceso maligno, para lo cual es importante realizar un frotis de sangre periférica para ver morfologías y tamaños de los glóbulos blancos, pudiéndose observar linfocitos atípicos o los activados en los síndromes mononucleares y otras infecciones víricas, o aquellos que presentaran formas características de determinados linfomas y otros síndromes linfoproliferativos, o la presencia de formas inmaduras, comunes en la Leucemia linfoide aguda.
Podemos complementar haciendo una completa exploración buscando sintomatología de linfoadenomegalias, esplenomegalia y hepatomegalia. También son útiles las pruebas de imagen que permitan sospechar etiología infecciosa o tumoral como radiografía de tórax y la ecografía abdominal. Si las sospechas se inclinaran hacia un diagnóstico presuntivo de infección se procedería a hacer pruebas serológicas específicas para detección de virus de la hepatititis, VIH, VEB o CMV. Si las adenopatías persistieran más de ocho semanas es recomendable hacer una biopsia de los ganglios afectados.
Referencias
Enlaces externos
- "Alteraciones analíticas frecuentes" (por "El Médico Interactivo" del diario electrónico de Sanidad)
- "Interpretación del Hemograma" (por la Dra. Ana Becker K.) Archivado el 25 de octubre de 2012 en Wayback Machine.
- "Linfocitosis aguda infecciosa" (por la Dra. Myriam Campbell y la Dra. Mireya Bravo L.)